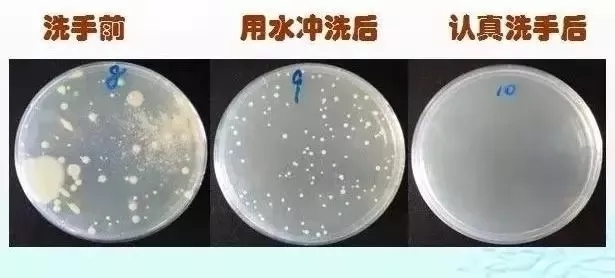

【疾控提醒】预防呼吸道传染病,正确洗手很重要


(记者贾湧强)北京市已进入呼吸道传染病高发季节,呈现流感病毒、腺病毒、呼吸道合胞病毒,肺炎支原体、新冠病毒等多种呼吸道病原体共同流行的态势,总体感染人数呈上升趋势。
正确洗手是预防传染病的重要措施。当用未清洁的手接触口鼻眼或伤口时,病原体会通过黏膜、呼吸道等途径进入体内,很多呼吸道疾病因为未及时正确的洗手造成了传播。那么如何正确洗手呢?
01、以下情况一定要洗手:
去医院、看护病人后。
外出或购物回家后。
处理宠物粪便后。
给孩子换尿布后。
擤鼻涕、上厕所后。
做饭、用餐、冲奶粉前。
摘戴隐形眼镜、揉眼睛前。
手部有明显污染物时。
02、洗手时不用香皂,只用水随便冲冲,效果怎么样?我们做了个实验来验证!
不洗手的话,培养基上可以看到大片的菌落,手经过流水冲洗后,菌落数少了一些,但还是有很多;用香皂认真洗手并擦干后,肉眼看不到细菌生长!
03、到底应该如何正确洗手

(信息来源:北京市疾病预防控制中心)


